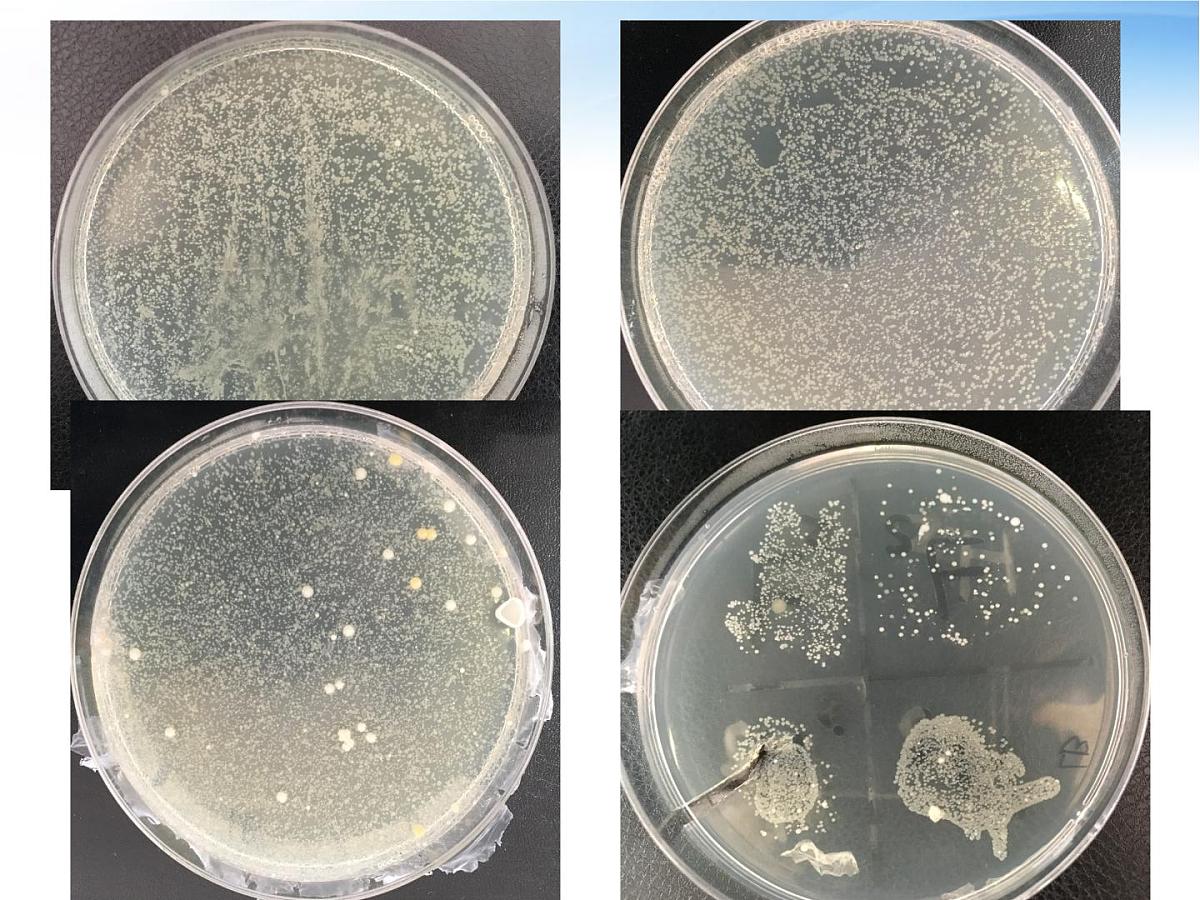
人教版 (新课标)高中生物必修3 2-4《免疫调节（第1课时）》课件第6页

高中生物人教版 (新课标)必修3《稳态与环境》免疫调节说课课件ppt
展开
这是一份高中生物人教版 (新课标)必修3《稳态与环境》免疫调节说课课件ppt,共30页。PPT课件主要包含了第4节免疫调节,免疫系统的组成,1免疫器官,免疫系统的功能,人体的三道防线,非特异性免疫,第三道防线,特异性免疫,体液免疫的过程,什么是抗体等内容,欢迎下载使用。
胸腺、骨髓、脾、淋巴结、扁桃体
(位于淋巴液、血液和淋巴结中)
抗体、淋巴因子(如干扰素或白细胞介素)、溶菌酶等
(发挥免疫作用的细胞)
T细胞(迁移到胸腺中成熟)
B细胞(在骨髓中成熟)
(由免疫细胞或其他细胞产生的发挥免疫作用的物质)
(免疫细胞生成、成熟或集中分布的场所)
淋巴细胞是怎么形成的呢?
(2)淋巴细胞的起源和分化
骨髓Bne marrw
(一)防卫功能(二)监控和清除功能
Hi, 大家好,我是HIV病毒!
且听故事:《HIV病毒历险记》,并根据故事完成学案相关内容。
人体的三道防线如何发挥作用?
皮肤像铜墙铁壁!我怎么也进不去。
不好,有伏兵!很多弟兄都遇难了。
啊! 黏膜上居然有纤毛和黏液!我们中的大部分被驱逐出境了。
弟兄们,皮肤上有伤口,冲啊! 哈哈!我和我的小伙伴们突破了第一道防线!
(体液中的杀菌物质和吞噬细胞)
特点:人人生来就有,对多种病原体都有一定的防御作用,不具特异性。
哈哈!没想到吧!我就是漏网之鱼,第二道防线,小case!
主要是由免疫器官和免疫细胞借助血液循环和淋巴循环组成
特点:对特定的病原体起作用,具有特异性。后天获得。
第三道防线是如何发挥作用的?
B细胞靠产生抗体来“作战”
T细胞靠直接接触靶细胞来“作战”
a. 在此过程中免疫活性物质有哪些?由什么细胞产生?各起了什么作用?b. 在此过程中哪个细胞没有发挥作用?
机体受抗原刺激后产生的,能与该抗原发生特异性结合的具有免疫功能的球蛋白。
①血清(主要)②组织液及外分泌液
引起机体产生特异性免疫反应的物质叫做抗原
(2)举例:病原体、细菌、花粉、癌细胞、衰老细胞等
(1)特点:异物性:①进入人体的外来物质,如细菌 ②非正常组织:如癌细胞衰老细胞特异性:只能与相应的抗体或效应细胞发生 特异性结合( 特异性基础:抗原表面具有抗原决定簇)
记忆细胞迅速增值分化,快速产生大量抗体
记忆细胞对抗原十分敏感,能“记住”入侵的抗原。对抗原的记忆可保持数月甚至终生。
二次免疫应答特点:更多、更快、更强
吞噬细胞(摄取和处理)
抗体与抗原结合,特异性免疫反应,例如形成沉淀或细胞集团,被吞噬细胞吞噬、消化
(更强的特异性免疫反应)
如何构建体液免疫的概念图?
相关课件 更多
- 1.电子资料成功下载后不支持退换,如发现资料有内容错误问题请联系客服,如若属实,我们会补偿您的损失
- 2.压缩包下载后请先用软件解压,再使用对应软件打开;软件版本较低时请及时更新
- 3.资料下载成功后可在60天以内免费重复下载
 免费领取教师福利
免费领取教师福利


.png)




